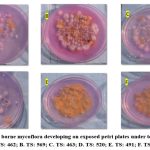

Introduction
Tea Camellia sinensis (L.) Kuntze is an out-breeding plantation crop, and as such, cross-pollination is essential to produce seeds and to get superior seeds from better hybrid progenies.1 Tea plants grown nearer to the equator flower throughout the year however, in north-east India, flowering of tea plants starts in October with a peak in November and December. It takes 120–150 days from the appearance of flower buds to their full anthesis.2 At present, the seed yields in tea seed orchards in Assam are low, ranging from 6 to 12.9 percent,3 which may be due to increasing pollution levels as pollutants are known to affect pollen germination.4 In tea seed orchards, flowers are openly pollinated by long-distance bees or wasps. The role of ants and unidentified black weevils, which are seen inside flowers very often, probably contributes greatly towards self-pollination.3 Pollen germination is affected by offsite application of agro pesticides,5 which may be attributed to the low yield of seeds. Tea flowers are known to contain similar health-promoting components and nutraceuticals as tea,6,7 and local people relish tea flowers as a unique source of nutrition supplements.
Currently, tea plants are propagated by two means: seeds and clones. The demand for seeds in the Indian tea industry is ever-increasing due to the adoption of an uprooting and replanting program.8 Tocklai Tea Research Institute, Jorhat, carried out intensive work on tea selection and conventional breeding in the past and released 14 biclonal seed stocks (TS:378, TS:379, TS:387, TS:449, TS:450, TS:462, TS:463, TS:464, TS:491, TS:506, TS:520, TS:557, TS:569, and TS:589). These seed stocks with different parental combinations are supplied to certified seed growers for establishing seed bars or seed orchards in different regions (Upper Assam, North Bank, Terai, Dooars, Darjeeling, and Tripura) of North East India.9 A seed bari in Terai is located at Gaya Ganga T.E. and was established with 13 biclonal seed stocks to fulfil the demands of seeds for the region, e.g., TS:378 (14.5.35 * 14.6.28) , TS:379 (14.5.35 * 14.12.16), TS:397 (TV1 * 9.35.2), TS :449 (TV1 * 19.31.14) ,TS:450 (TV2 * 270.2.13), TS 462 (TV1 * 124.48.8) TS:462 (TV1 * 124.48.8), , TS:463 (TV1 * TV19)TS: 464 (TV1 * 19.29.2) ,TS:491 (TV1 * S3A/1) , TS:520 (TV19 * TV20). There are clonal nucleus nursery plants of the following tea varieties: TV: 19, 16–18, 20–30, CP: 1, MG: 25, 124–48/8, T3E3, S3A3, S3A1, RR-17/144, P–126, and T–78.
Mature tea seeds, after pollination, drop underneath the tea seed plants and, as such, get contaminated with different species of fungi from the soil. Besides airborne mycoflora, they remain associated with leaves, growing capsules, and the surface of seeds. Fungi like Fusarium, Alternaria, Aspergillus, Cladosporium and Penicillium, colonize seed surfaces and are known to produce mycotoxin. Fungal deterioration of tea seeds caused by airborne mycoflora is a significant constraint for seed growers, and fungal mycotoxin-producing activities are likely to increase due to climate change and global warming.10
Air pollution causes annual mortality of 9 million people globally and is a growing problem and pose a significant environmental and public health challenges in the face of climate change particularly in developing countries.11 Rapid industrialization, urbanization, destruction of forests for infrastructure, and construction of urban housing have caused emissions of GHGs like CO2, NO2, and CH4 that have influenced the air quality index. WHO has recently revised air quality guidelines to include stricter limits.12 Air is composed of various types of gases in different proportion e.g., carbon monoxide (CO), Nitrous oxide (NO), Sulphur dioxide (SO2), formaldehyde, polycyclic organic matter in the form of Benzopyrene suspended as aerosol. Exposure to airborne particulate matter (PM10, PM2.5), pollutants containing fungi, pollen grains, bacteria, actinomycetes, algae, etc. and their secondary metabolites can result in respiratory disorders and other adverse health effects such as allergy, infection, hypersensitivity pneumonitis, and toxic reactions.13,14 In India death due to air pollution reaches as high as 1.6 million annually including 28,799 premature deaths.15
Most scientific literature shows the negative impact of microbes and is over emphasized at times without critical evaluation. Microbes perform various ecosystem services, including carbon cycle, decomposition of debris, soil health, occupying the rhizosphere zone and contributing to plant health. Airborne fungi influence plants, animals, humans, and some microbes remain intimately associated as endophytes or gut flora and produce metabolites.16,17 Bioactive compounds produced by fungi comprise over 8600 compounds, accounting for 38% of all microbial sources.18 These microbes in humans, animals, and plants influence the hosts’ physiology and immune system positively. Microbes are transported vertically to the next generation through seeds and benefit the host’s offspring. There is ample evidence of the continuous exchange of microbes among humans, animals, plants, and the environment. However, the use of antifungal agents and antibiotics can inhibit the growth and development of microbes and give rise to antimicrobial resistance.
Aerobiology in India was studied by Cunningham in1889 at Calcutta, and Gregory in 1967 published a book entitled “Microbiology of the Air”. Later, a comprehensive review of Indian aerobiology was compiled.19 The Indian Aerobiological Society was established under the presidency of the late Prof. Sunirmal Chanda in 1980.
Fungal foliar plant pathogens of tea include Pestalotiopsis theae, Colletotrichum camelliae, Exobasidium vexans, Fusarium solani, Fusarium oxysporum, Cephaleuros parasiticus (algal disease), Phomosis theae, Poria hypobrunnea, etc. Spores are released within the plant surface in the boundary layer, and some spores escape the boundary layer to enter the general air spore. Spores that have an active discharge mechanism can escape the laminar flow effect of the boundary layer and travel a long distance. Exobasidium vexans, which causes blister blight disease in tea, has active discharge mechanism, and therefore basidiospores spread far and wide. On the other hand, spores of Pestalotiopsis, Fusarium and Colletotrichum remain aggregated as mucilaginous masses and spread primarily by rain splash.
The aim of the study is to investigate the period of flowering and diversity of air mycoflora prevalent in six biclonal tea seed orchards (TS:569, TS:491, TS:557, TS:520, TS:463, TS:462) in Gaya Ganga Tea Estate.
Materials and Methods
Aero mycological study was carried out at seed orchards of Gaya Ganga T.E. of Darjeeling District of West Bengal in between of Latitude 26.6101° N. and Longitude 88.3037° E.). Observation on flowering time of seed baries was recorded during 2022 – 2023.
Air sampling was carried out by a portable Microbial sampler, the MicroBio MB1, manufactured and supplied by Cantium Scientific Limited, Dartford Kent, UK. The sampler has an air flow rate of 10–100 l/min. The sampler collects airborne organisms by drawing a stream of air at a constant flow rate through a series of small holes in a metal head. Viable spores, conidia, and hyphal filament particles suspended in an air stream impinge on the surface of a sterile culture medium in a contact plate or Petri dish.
The sampler was placed about 2 feet above ground level beneath tea seed plants between 10 and 11 a.m. on December 25, 2022. A triplicate disposable sterile Petri plate (8cm dia.) containing Rose Bengal Chloramphenicol agar was used. Plates were sealed after exposure, incubated at 30°C in the laboratory for 72 hours and counted after the appearance of fungal colonies.
The colonies of fungi were examined under low and high magnification using light microscope and later identified with the help of available literature.20,21,22
Quantitative compositions of mycoflora were determined by counting the number of total colonies and percent occurrence of individual taxa was obtained as per following formula given by,23 with slight modification.
![]()
Colony forming unit per cubic meter was calculated as per following formulae given by,23 with slight modification.

Where Nc is the number of colonies and Vs is the sampled volume in litres.
Results and Discussion
Table 1: Observation on flowering time of seed orchards was recorded during 2022 – 2023.
| Months
|
Weeks | Remarks | |||
| 1 | 2 | 3 | 4 | ||
| September 22 | 0 | 0 | 0 | + | Bud Initiation |
| October 22 | + | + | ++ | ++ | Bee activity observed |
| November 22 | +++ | ++++ | ++++ | ++++ | Opening of buds and Flower development
Pollination and dropping of petals. Peak of bee activity. Long distance bee and hornets observed |
| December 22 | +++ | ++ | ++ | ++ | Pollination and dropping of petals underneath the bush |
| January 23 | + | + | + | + | -do- |
| February 23 | + | + | + | 0 | -do- |
[Note: + = 1-25%; ++ = 26-50%; +++ = 51-75%; ++++ = 76-100% of flowering]
It was observed that bud initiation was seen during the 4th week of September, while the peak of flowering was from the 2nd to the 4th week of November in 2022. Flowering of plants slowly declined from the second week of December to trace or no flowering by the end of February. Bee activity was observed in October and long-distance bee, hornets were seen visiting tea seed plants during flowering. The flower, comprising petals and androecium attached to it, drops off the ground below within 48 hours of pollination. The flowers are collected by locals and workers for consumption as nutritious food.
Table 2: Percentage occurrence of individual taxa
| Fungal species | TS:569 | TS:491 | TS:557 | TS:520 | TS:463 | TS:462 |
| CFU/M3 | CFU/M3 | CFU/M3 | CFU/M3 | CFU/M3 | CFU/M3 | |
| Penicillium mallochi | 1240 | 80 | 520 | 150 | -0- | 50 |
| Penicillium chrysogenum | -0- | -0- | -0- | -0- | 160 | 320 |
| Cladosporium sp | 300 | -0- | 20 | 180 | 20 | -0- |
| Aspergillus niger | 40 | 20 | -0- | -0- | -0- | 10 |
| Penicillium purpurogenum | -0- | 640 | -0- | 10 | -0- | -0- |
| Total | 1580 | 740 | 540 | 340 | 180 | 380 |
It was evident from the Table 2 that quantitative and qualitative composition of air mycoflora varied widely among the different tea seed orchard. Maximum population of mycoflora (CFU 1580/M3) was recorded under TS: 569 and lowest (CFU 180/M3) under TS: 463. Air mycoflora fluctuated under TS: 491, TS: 557, TS: 520 and TS: 462 were CFU 740/M3, CFU 540/M3, CFU 340/M3 and CFU 380/M3 respectively. (TS-Tea Seed).
![]() |
Figure 1: Air borne mycoflora developing on exposed petri plates under tea seed baries. [A. TS: 462; B. TS: 569; C. TS: 463; D. TS: 520; E. TS: 491; F. TS: 557]. |
Qualitatively, a total of three Penicillium species, one Aspergillus niger and one Cladosporium species were recorded. The dominance of Penicillium spp. over other species was observed during the period of study. The high population of Penicillium colonies (P. chrysogenum and P. malochi) may be attributed to increased colonization of flowers that drop on the ground after pollination. The deep orange colour produced by Penicillium was found to be closely related to monoverticillate P. mallochi. Monoverticillate Penicillium is found to be potent producers of red or orange-red pigment24. The genus Penicillium was introduced by Link in 1809, probably indicating similarity with brush, and he described three species: P. candidum, P. glaucum, and P. expansum. The taxonomy of Penicillium is highly complex due to the introduction of one fungus with one name by the International Botanical Nomenclature Committee in Melbourne, 2012. The genus Penicillium currently contains 354 accepted species.25 The genus Penicillium has profound agricultural,26,27 environmental,27 food, and medical importance.28,29 The first ever antibiotic penicillin was obtained from P. notatum and P. chrysogenum, which were discovered by A. Flemming in 1943. Many of the species of Penicilium produce mycotoxins, e.g., patulin, citrinin, rubratoxin, cyclopiazonic acid, and ochratoxin, which are produced by P. patulum, P. citrinum, P. rubrum, P.cyclopium and P. verrucosum, respectively. Species of Penicillium are also found to produce pigments that are currently used commercially as food colouring.30,31 Deep red pigment is produced by P. cyclopium and P. viridicum,27 while orange pigment is produced by P. purpurogenum and P. marhneffi . During the study of diurnal variation of air mycoflora over a tea plantation in plains of Darjeeling district, observed the dominance of Cladosporium (71% of the total) over other air mycoflora.32 Aspergillus niger was dominant over the standing tea.33
![]() |
Figure 2: Showing air borne fungal spores [A. Penicillium mallochi; B. Penicillium chrysogenum; C. Aspergillus niger; D. Cladosporium spp]. |
Aspergillus also produces different types of toxins, such as aflatoxins (A. flavus, A. parasiticus, and A. nomius) and ochratoxins (A. carbonarious and A. ochraceous). Besides, species of Aspergillus are widely used in different industrial applications, including the production of foods, drinks, organic acids (citric acid), and a large variety of enzymes (A. niger, A. aculeatus and A. oryzae).34,35 Lovastatin, a cholesterol-lowering drug, is produced by A. terreus.36 Research on Aspergillus occupies one of the priority areas in global academic, R & D and industrial institutes. In food industry A. niger has been accorded GRAS (Generally Recognized As safe) status by the US FDA.35 Species of Aspergillus are cosmopolitan and occur in different ecosystems in a wide range of environmental and climatic zones.37,38 They are capable of colonizing a wide variety of substrates differing in chemical composition.39 They are found throughout the world in soil,40,41,42,43 salt-producing areas,44,45 agroecosystems,46,47,48,49 polar environment,50 living plants, animals, and lichens,51 stones, water-related areas,52 fossil specimens,53,54 and human allergy and respiratory ailment.55,56 A. niger produces a range of secondary metabolites and mycotoxins and has been comprehensively reviewed. A. niger has also been explored as a biocontrol agent for Fusarium wilt in tomatoes.57
Cladosporium sp were observed under Tea seed orchards TS:569, TS:557, TS:520, and TS:463 with 300, 20, 180, and 20 cfu/M3, respectively. In tea orchards, more than one species of Cladosporium spp. was found to colonize the anther and petals of flowers, which drop off after pollination, and probably serve as the primary source besides the phylloplane environment. It has been stated that phylloplane mycoflora serve as a major source of airborne fungi.58 In the tea ecosystem, leaves serve as habitat for the growth and survival of Cladosporium, the dominant species on the ventral surface.59
The fungus Cladosporium was described by H.F. Link in 1816 with C. herbarum as the type species. The genus Cladosporium sp now has an estimated 772 species.60
Cladosporium species are cosmopolitan in distribution and commonly encountered on plant, fungal and other debris, compost, decayed flower petals, soil, food materials, wet walls, wall paintings, textiles, and other organic matters, or colonize as secondary invaders leaf lesions caused by plant pathogenic fungi.61,62 Some species are hyperparasites,63 endophytes,64,65 and components of phylloplane fungi.66,67,68,69,70 Some species cause human respiratory ailments.
Conclusion
The flowering time of tea plants in foothills of Darjeeling district starts at the end of September and November is the peak flowering time. Tea flowers serve as reliable sources of nutrition supplements for humans. The maximum population of mycoflora (CFU 1580/M3) was recorded under TS 569 and the lowest (CFU 180/M3) under TS 463. Air mycoflora fluctuated under TS: 491, TS: 557, TS: 520 and TS: 462 and were CFU/M3, 740, 540, 340 and 380 respectively. Red-pigmented species i.e., Penicillium malochi found to be dominant over Aspergillus niger and Cladosporium sp.
The low diversity of mycoflora observed in the present study may be attributed to the low temperatures prevailing during the period of sampling. The normal path of air flow under tea orchards gets altered due to the growth of tea plants to a height of 3–4 meters or more. A possible reason for the low incidence may be attributed to the leaf surfaces of plants, which might act as traps for airborne mycoflora as well as dust, which reduce the load as compared to open air. This aspect remains a research gap. There is a need to carry out seasonal variation of air mycoflora in tea seed orchards. Future studies aim at exploring the role of these mycoflora on seed health and seed output.
Acknowledgment
Authors are grateful to the Management of Gaya Ganga T.E. for permission to visit the Estate and carry out the work. Authors are also grateful to Dr. Sukumar Debnath for providing Portable Microbial Air Sampler for the present study and valuable suggestions in planning the entire work programme.
Conflict of Interest
There is no conflict of interest.
References
- Wight W. Selection of seed barie(1961). Two and a bud. 8(1): 9-11.
- Barua, P. K. (1970). Flowering Habit and Vegetative Behaviour in Tea (Camellia sinensis L) Seed Trees in North-East India. Annals of Botany, 34(3), 721-735.
CrossRef - Bezbaruah, H. P. (1974). Pollination in Tea [Camellia Sinensis (L) O. Kuntze] in North-East India. Journal of Plantation Crops, 2(2), 6.
- Ugale, C., Tidke, J. A., & Korekar, G. (2023). Pollen germination significantly affected by SO2, NOx, PM10 and AQI in the Amravati City of Maharashtra, India. Aerobiologia, 1-11.
CrossRef - Debnath S. Sensitivity of tea pollen grains to pesticides. Abstract 13th National Conference on Aerobiology, Indian Aerobiological Society, 2005.
- Lin, Y. S., Wu, S. S., & Lin, J. K. (2003). Determination of tea polyphenols and caffeine in tea flowers (Camellia sinensis) and their hydroxyl radical scavenging and nitric oxide suppressing effects. Journal of agricultural and food chemistry, 51(4), 975-980.
CrossRef - Yang, Z., Xu, Y., Jie, G., He, P., & Tu, Y. (2007). Study on the antioxidant activity of tea flowers (Camellia sinensis). Asia Pacific journal of clinical nutrition, 16.
- Barua, D. N. (1989). Science and Practice in Tea Culture, Tea Res. Association, Calcutta, Jorhat.
- Das S.C., Bordoloi. Tea seed Production. In Field Managements in Tea. Tea Research Association. Tocklai Tea Research Institute, Jorhat. Assam.2005;34-43.
- Paterson, R. R. M., & Lima, N. (2017). Thermophilic fungi to dominate aflatoxigenic/mycotoxigenic fungi on food under global warming. International journal of environmental research and public health, 14(2), 199.
CrossRef - Bruce, N., Perez-Padilla, R., & Albalak, R. (2000). Indoor air pollution in developing countries: a major environmental and public health challenge. Bulletin of the World Health organization, 78(9), 1078-1092.
- Ouyang, H., Tang, X., Kumar, R., Zhang, R., Brasseur, G., Churchill, B., … & Patdu, M. K. (2022). Toward better and healthier air quality: Implementation of WHO 2021 global air quality guidelines in Asia. Bulletin of the American Meteorological Society, 103(7), E1696-E1703.
CrossRef - Ouyang, H., Tang, X., Kumar, R., Zhang, R., Brasseur, G., Churchill, B., … & Patdu, M. K. (2022). Toward better and healthier air quality: Implementation of WHO 2021 global air quality guidelines in Asia. Bulletin of the American Meteorological Society, 103(7), E1696-E1703.
CrossRef - Pasanen, A. L., Lappalainen, S., & Pasanen, P. (1996). Volatile organic metabolites associated with some toxic fungi and their mycotoxins. Analyst, 121(12), 1949-1953.
CrossRef - Pandey, A., Brauer, M., Cropper, M. L., Balakrishnan, K., Mathur, P., Dey, S., … & Dandona, L. (2021). Health and economic impact of air pollution in the states of India: the Global Burden of Disease Study 2019. The Lancet Planetary Health, 5(1), e25-e38..
CrossRef - Hanski, I., von Hertzen, L., Fyhrquist, N., Koskinen, K., Torppa, K., Laatikainen, T., … & Haahtela, T. (2012). Environmental biodiversity, human microbiota, and allergy are interrelated. Proceedings of the National Academy of Sciences, 109(21), 8334-8339.
CrossRef - Hyde, K. D., Xu, J., Rapior, S., Jeewon, R., Lumyong, S., Niego, A. G. T., … & Stadler, M. (2019). The amazing potential of fungi: 50 ways we can exploit fungi industrially. Fungal Diversity, 97, 1-136.
CrossRef - Berdy J (2005). Bioactive microbial metabolites. The Journal of antibiotics.58(1):1-26.
CrossRef - Sreeramulu T (1967). Aerobiology in India. JOURNAL OF SCIENTIFIC & INDUSTRIAL RESEARCH. 26(11):474.
- Subramanian, C. V. (1971). Hyphomycetes. An account of Indian species, except Cercosporae. An account of Indian species, except Cercosporae.
- Barnett, H. L., & Hunter, B. B. (1972). Illustrated genera of imperfect fungi. Illustrated genera of imperfect fungi., (3rd ed).
- Seifert, K. A., & Gams, W. (2011). The genera of Hyphomycetes–2011 update. Persoonia-Molecular Phylogeny and Evolution of Fungi, 27(1), 119-129.
CrossRef - Senior, B. W. (1996). Examination of water, milk, food and air. Practical medical microbiology, 14, 883-921.
- Visagie, C. M., Houbraken, J., Rodriques, C., Pereira, C. S., Dijksterhuis, J., Seifert, K. A., … & Samson, R. A. (2013). Five new Penicillium species in section Sclerotiora: a tribute to the Dutch Royal family. Persoonia-Molecular Phylogeny and Evolution of Fungi, 31(1), 42-62.
CrossRef - Visagie, C. M., Houbraken, J., Frisvad, J. C., Hong, S. B., Klaassen, C. H. W., Perrone, G., … & Samson, R. A. (2014). Identification and nomenclature of the genus Penicillium. Studies in mycology, 78(1), 343-371.
CrossRef - Pitt, J. I., & Hocking, A. D. (2009). Fungi and food spoilage(Vol. 519, p. 388). New York: Springer.
CrossRef - Frisvad, J. C., Smedsgaard, J., Larsen, T. O., & Samson, R. A. (2004). Mycotoxins, drugs and other extrolites produced by species in Penicillium subgenus Penicillium. Mycol, 49, 201-241.
- Fleming, A. (1943). Streptoeoecal Meningitis treated With Penicillin. Measurement of Baeteriostatic Power of Blood and Cerebrospinal Fluid. Lancet, 434-8.
CrossRef - Chain, E., Florey, H. W., Gardner, A. D., Heatley, N. G., Jennings, M. A., Orr-Ewing, J., & Sanders, A. G. (1940). Penicillin as a chemotherapeutic agent. The lancet, 236(6104), 226-228.
CrossRef - Dufossé, L. (2018). Microbial pigments from bacteria, yeasts, fungi, and microalgae for the food and feed industries. In Natural and artificial flavoring agents and food dyes(pp. 113-132). Academic Press.
CrossRef - Kalra, R., Conlan, X. A., & Goel, M. (2020). Fungi as a potential source of pigments: Harnessing filamentous fungi. Frontiers in Chemistry, 8, 369.
CrossRef - Debnath S and Tiwari. A Quantification of air mycoflora over tea plantation in West Bengal. Souvenir 22nd National Conference on aerobiology and its impact on plant animal and human health
- Debnath, S., and Baruah, P. K (2008). Seasonal variation of mycoflora over tea plantation in Jorhat District, Assam. Indian J. Aerobiol. 21(2):79-83.
- Tong, W., Yu, J., Wu, Q., Hu, L., Tabys, D., Wang, Y., … & Bennetzen, J. L. (2021). Black tea quality is highly affected during processing by its leaf surface microbiome. Journal of Agricultural and Food Chemistry, 69(25), 7115-7126.
CrossRef - Schuster, E., Dunn-Coleman, N., Frisvad, J. C., & Van Dijck, P. W. (2002). On the safety of Aspergillus niger–a review. Applied microbiology and biotechnology, 59, 426-435.
CrossRef - Zaidan, K. I., & Azal, A. A. R. (2015). Molecular ecological typing of wild type Aspergillus terreus from arid soils and screening of lovastatin production. African Journal of Microbiology Research, 9(8), 534-542.
CrossRef - Klich, M. A. (2002). Biogeography of Aspergillus species in soil and litter. Mycologia, 94(1), 21-27.
CrossRef - Lević, J., Gošić-Dondo, S., Ivanović, D., Stanković, S. Ž., Krnjaja, V., Bočarov-Stančić, A. S., & Stepanić, A. (2013). An outbreak of Aspergillus species in response to environmental conditions in Serbia. Pesticidi i fitomedicina, 28(3), 167-179.
CrossRef - Flannigan, B., & Pearce, A. R. (1994). Aspergillus spoilage: spoilage of cereals and cereal products by the hazardous species A. clavatus. The Genus Aspergillus: From Taxonomy and Genetics to Industrial Application, 115-127.
CrossRef - Hill, R. A., Blankenship, P. D., Cole, R. J., & Sanders, T. H. (1983). Effects of soil moisture and temperature on preharvest invasion of peanuts by the Aspergillus flavus group and subsequent aflatoxin development. Applied and environmental microbiology, 45(2), 628-633.
CrossRef - Abdel-Azeem, A. M., & Ibrahim, M. E. (2004). Diversity of terrophilous mycobiota of Sinai. Egyptian Journal of biology, 6.
- Conley, C. A., Ishkhanova, G., Mckay, C. P., & Cullings, K. (2006). A preliminary survey of non-lichenized fungi cultured from the hyperarid Atacama Desert of Chile. Astrobiology, 6(4), 521-526.
CrossRef - Jaime-Garcia, R., & Cotty, P. J. (2006). Spatial relationships of soil texture and crop rotation to Aspergillus flavus community structure in South Texas. Phytopathology, 96(6), 599-607.
CrossRef - Butinar, L., Frisvad, J. C., & Gunde-Cimerman, N. (2011). Hypersaline waters–a potential source of foodborne toxigenic aspergilli and penicillia. FEMS Microbiology Ecology, 77(1), 186-199.
CrossRef - Kahlil, W. F., Abdel-Azeem, A. M., & Balbol, B. A. (2013). Bioprospecting as a conservation tool: the genus Aspergillus (Eurotium) in Egypt [42].
CrossRef - Bayman, P., Baker, J. L., Doster, M. A., Michailides, T. J., & Mahoney, N. E. (2002). Ochratoxin production by the Aspergillus ochraceus group and Aspergillus alliaceus. Applied and environmental microbiology, 68(5), 2326-2329.
- Horn, B. W. (2003). Ecology and population biology of aflatoxigenic fungi in soil. Journal of Toxicology: Toxin Reviews, 22(2-3), 351-379.
CrossRef - Muthomi, J. W., Mureithi, B. K., Chemining’wa, G. N., Gathumbi, J. K., & Mutit, E. W. (2012). Aspergillus species and Aflatoxin b1 in soil, maize grain and flour samples from semi-arid and humid regions of Kenya. International Journal of AgriScience, 2(1), 22-34.
- Marín, S., Ramos, A. J., & Sanchis, V. (2012). Modelling Aspergillus flavus growth and aflatoxins production in pistachio nuts. Food microbiology, 32(2), 378-388.
CrossRef - Arenz, B. E., Blanchette, R. A., & Farrell, R. L. (2014). Fungal diversity in Antarctic soils. In Antarctic terrestrial microbiology: physical and biological properties of Antarctic soils(pp. 35-53). Berlin, Heidelberg: Springer Berlin Heidelberg.
CrossRef - Tripathi, M., & Joshi, Y. (2015). Endolichenic fungi in Kumaun Himalaya: a case study. Recent Advances in Lichenology: Modern Methods and Approaches in Lichen Systematics and Culture Techniques, Volume 2, 111-120.
CrossRef - Sivakumar, T., Ravikumar, M., & Sivakumar, N. (2006). Abundance of mangrove fungi along the east coast of Tamil Nadu, India. Asian Journal of Microbiology, Biotechnology and Environmental Sciences, 8(3), 589-594.
- Thomas, G. M., & Poinar Jr, G. O. (1988). A fossil Aspergillus from Eocene Dominican amber. Journal of Paleontology, 141-143.
CrossRef - Dörfelt, H., & Schmidt, A. R. (2005). A fossil Aspergillus from Baltic amber. Mycological Research, 109(8), 956-960.
CrossRef - Horner, W. E., Helbling, A., Salvaggio, J. E., & Lehrer, S. B. (1995). Fungal allergens. Clinical microbiology reviews, 8(2), 161-179.
CrossRef - Findley, K., Oh, J., Yang, J., Conlan, S., Deming, C., Meyer, J. A., … & Segre, J. A. (2013). Topographic diversity of fungal and bacterial communities in human skin. Nature, 498(7454), 367-370.
CrossRef - Sharma, B. K., Loganathan, M., Singh, R. P., Bag, T. K., Rai, R. K., Rai, A. B., & Rai, M. (2011). Aspergillus niger, a potential biocontrol agent for controlling fusarial wilt of tomato. Journal of Mycopathological Research, 49(1), 115-118.
- Levetin, E., & Dorsey, K. (2006). Contribution of leaf surface fungi to the air spora. Aerobiologia, 22, 3-12.
CrossRef - Debnath, S (1985). A note on tea leaf surface mycoflora from Darjeeling. Two Bud. 32(1-2):62-64.
CrossRef - Dugan, F. M., Schubert, K., & Braun, U. (2004). Check-list of Cladosporium names. Schlechtendalia, 11, 1-103.
- Ellis, M. B. (1971). Dematiaceous Hyphomycetes CMI: Kew. UK. 608pp.
- Ellis, M. B. (1976). More dematiaceous Hyphomycetes. CMI. Kew, England, 41.
- Heuchert, B., Braun, U., & Schubert, K. (2005). Morphotaxonomic revision of fungicolous Cladosporium species (hyphomycetes). Schlechtendalia, 13, 1-78.
- Riesen, T. K. (1985). Endophytic fungi in winter wheat (Triticum aestivum L.): a comparison between four wheat cultivars with different resistance to Phaeosphaeria nodorum (Müller) Hedjaroude(Doctoral dissertation, ETH Zurich).
- El-Morsy, E. M. (2004). Evaluation of microfungi for the biological control of water hyacinth in Egypt. Fungal Divers, 16, 35-51.
- Islam, M., & Hasin, F. (2000). Studies on the phylloplane mycoflora of Amaranthus viridis. L. National Academy Science letters, 23(9-10), 121-123.
- De Jager, E. S., Wehner, F. C., & Korsten, L. (2001). Microbial ecology of the mango phylloplane. Microbial ecology, 201-207.
CrossRef - Inácio, J., Pereira, P., Carvalho, D. M., Fonseca, A., Amaral-Collaco, M. T., & Spencer-Martins, I. (2002). Estimation and diversity of phylloplane mycobiota on selected plants in a mediterranean–type ecosystem in Portugal. Microbial Ecology, 44, 344-353.
CrossRef - Stohr, S. N., & Dighton, J. (2004). Effects of species diversity on establishment and coexistence: A phylloplane fungal community model system. Microbial Ecology, 48, 431-438.
CrossRef - Debnath .S and P.K.Baruah. Influence of phylloplane microflora of tea ,Camellia sinensis (L).O.Kuntze on germination of Exobasidium vexans Research Journal of contemporary concern.(10-11) 139-147.